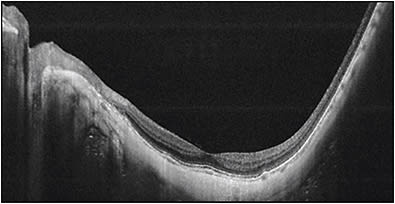
Figure 3. Steepened scleral curvature by OCT, which is confused with staphyloma. Swept-source OCT image across the fovea and the optic nerve shows the scleral curvature is steepened. However, there is no outpouching of the limited area of posterior sclera, suggesting posterior staphyloma.

Posterior staphyloma, the posterior outpouching of the wall of the eye, is an important component of the diagnosis of pathologic myopia; indeed, it is one of the hallmarks of pathologic myopia.1-5 With the exception of inferior staphyloma related to tilted disc syndrome, it does not occur in pathologies other than pathologic myopia. Thus, the presence of staphyloma is specific to pathologic myopia and critically important in differentiating simple school myopia with good best corrected visual acuity (BCVA) and pathologic myopia that could cause the loss of BCVA.
This review shows the current definition, clinical characteristics, and a classification based on the recent imaging technologies for posterior staphyloma. Future approaches to treat and prevent staphyloma are also mentioned.
DEFINITION OF POSTERIOR STAPHYLOMA
There is some confusion about the definition of posterior staphyloma. The steepened curve of the posterior sclera, caused by an axial elongation, has tended to be confused with a staphyloma in some optical coherence tomography (OCT) studies.
In Pathologic Myopia2 (Figure 1), Spaide clearly defines posterior staphyloma as “an outpouching of the wall of the eye that has a radius of curvature that is less than the surrounding curvature of the wall of the eye.” The author added nasally distorted eye shape to the definition based on results of three-dimensional magnetic resonance imaging (3D MRI) study.4

Staphyloma also can occur in eyes that do not have long axial length. Curtin1 showed that in eyes with type I staphyloma, the most common type, the axial length ranged from 25 mm to 38 mm. He therefore emphasized that axial length was not a reliable marker to define pathologic myopia, and he concluded that pathologic myopia should be defined by the presence of staphyloma. Wang et al6 recently reported clinical features of staphylomas in eyes whose axial lengths measured fewer than 26.5 mm. Thus, outpouching of the wall of eyes without long axial length is also considered to be posterior staphyloma (Figure 1D).
METHODS TO DETECT POSTERIOR STAPHYLOMA
Problems with Conventional Methods
The most common methods to detect staphylomas have been color fundus photography and ultrasonography. Especially, conventional 50° fundus photos are widely used in many epidemiological studies. However, most staphylomas involve wide areas of the fundus (especially the upper and temporal direction), and thus the entire extent of the staphyloma does not fit within the 50° field of view of conventional fundus photographs (Figure 2). Similarly, in most cases, staphylomas are too wide to fit into the length of an OCT scan (Figure 3).

3D MRI
To overcome these problems, Moriyama and the author4,7,8 established a new technique called 3D MRI to analyze the entire shape of the eye (Figure 4). The 3D MRI technique is well suited to examine the eye shape over a wide area that can encompass even a large posterior staphyloma from any angle. The author used 3D MRI and reported posterior outpouching of the globe, suggesting staphyloma was observed in 50.5% of the eyes with mean axial length of 30.0 mm.4 More recently, the author used a combination of 3D MRI and Optos in Japanese and Spanish patients and reported a similar prevalence (55% of the eyes with mean axial length of 30.5 mm).9 These data also showed that even among very long eyes (axial length of 30 mm) about a half of them do not have posterior staphylomas; they were simply elongated in an anteroposterior direction.9

The most predominant type was wide macular staphyloma (74% of eyes with staphyloma), followed by narrow macular staphyloma (15% of eyes with staphyloma).
WIDEFIELDS: FUNDUS IMAGING AND OCT
Despite the usefulness of 3D MRI, it is still difficult to perform in a large population of patients in routine clinical settings. It also remains difficult to perform 3D MRI due to availability and cost. As a surrogate, the author and colleagues4,9 used widefield fundus imaging by the Optos system and analyzed the presence of staphyloma by examining pigmentary abnormalities along the upper edge of staphyloma. However, the disadvantage of widefield imaging lies in a lack of 3D information.
To solve these issues, we are conducting ongoing studies using a prototype ultra-widefield OCT by Canon Inc. (Tokyo) in our institute. In the near future, this technique will become a cost-effective and more available tool to evaluate the presence and types of staphyloma. Different from 3D MRI, widefield OCT can also visualize how the retina and optic nerve are damaged by eye deformity (Figure 5). This is important because it can demonstrate the exact cause of vision-threatening complications in pathologic myopia.

CHARACTERISTICS OF POSTERIOR STAPHYLOMA
Prevalence
Because detection methods differ among various studies, making a direct comparison to discern the prevalence of staphyloma is difficult. The prevalence of staphyloma tends to increase with an increase of axial length in general. Curtin10 used stereoscopic funduscopy and reported that the staphyloma was present in 4.8% of the eyes with axial length of 27.5 mm to 28.4 mm. Its prevalence increased to 32.9% in the eyes with axial length between 29.5 mm to 30.4 mm.
CLASSIFICATION
Curtin’s Classification
Based on stereoscopic fundus observations, Curtin1 classified posterior staphylomas in eyes with pathologic myopia into 10 types (Figure 6). Types I to V were considered primary staphylomas and types VI to X were combined staphylomas. This is the most frequently used classification; however, it is determined from ophthalmoscopic appearances, which might be rather subjective.

The Author’s Modified Classification
To overcome these issues with Curtin’s classification, the author4 determined the type of staphylomas based on the shape of the entire eye using scans by 3D MRI. To simplify Curtin’s classification, the author analyzed only the contour of the outermost border of staphylomas. This resulted in Curtin types VI to X being placed into the type I category. The staphyloma type is renamed according to its location and distribution; this facilitates with memorization. (Figure 7).

In Pathologic Myopia, Spaide published images of staphylomas that do not belong in any type in Curtin’s classification.2 Thus, the further improvement of imaging technologies of eye shape (like widefield OCT) may reveal a much more complicated pattern of staphylomas, and new classification is expected to be made according to such future modalities.
Among staphylomas, the wide macular type was by far the most common (74% of all staphylomas) (Figure 8). The narrow macular type followed (14%) (Figure 9). Other types are rare, and they include inferior staphyloma (3%) and nasal staphyloma (2%).


CLINICAL SIGNIFICANCE OF STAPHYLOMAS
Eyes with posterior staphyloma have been reported to have worse outcome functionally and structurally than the eyes with simple axial myopia but without staphyloma.
The author4 investigated how staphylomas affect the functional and anatomical properties of the eye and showed that eyes with staphylomas had significantly worse BCVA and more eyes had patchy chorioretinal atrophy and myopic choroidal neovascularization than eyes without evident staphylomas. These data confirmed that the formation of staphylomas had a significant unfavorable effect on patients with pathologic myopia.
This detrimental effect might be due to the great expansion of the area of the posterior pole of the eye, as suggested by Spaide.2 As shown in Figure 1, the posterior fundus is stretched even by a simple elongation of the axial length in axial myopia, but the area could not be doubled because the equatorial region mainly elongates and contributes to axial length increase. However, when an outpouching develops, the original area including macula and optic nerve could be greatly expanded and could double. So, it is easy to expect that the mechanical expansion of the occupied area is no comparison between the eyes with and without staphylomas.
TOWARD FUTURE TREATMENTS TARGETING STAPHYLOMAS
Future therapeutic approaches for pathologic myopia would be to prevent and treat the staphylomas, because staphylomas may be a cause of worse visual and anatomical outcome for patients with pathologic myopia. Although some lesions of myopic maculopathy have treatment options (like antivascular endothelial growth factor therapies for myopic choroidal neovascularization and surgeries for myopic traction maculopathy), visual improvements are limited in most cases.
In addition, other lesions (chorioretinal atrophy and optic nerve damage) have no treatments to improve vision. Thus, preventive therapies targeting staphylomas before serious complications occur would be ideal and expected. These could include scleral collagen crosslinking,11 scleral reinforcement, and scleral regeneration. Shinohara and colleagues12 recently succeeded in preventing myopia in rat models of experimental myopia by regenerating scleral collagen by an implantation of skin fibroblasts.
In addition, Jonas13 have found that the status of Bruch’s membrane may alter the scleral curvature. Thus, in the future, therapies targeting Bruch’s membrane may also become a promising approach to prevent staphyloma development.
CONCLUSION
As Curtin suggested some 40 years ago, posterior staphyloma is the most important feature of pathologic myopia. Because staphylomas occur even in eyes without long axial length and the since staphyloma development significantly affects the outcome of myopic patients, pathologic myopia should be considered, by definition, by the presence of staphylomas and not by refractive error or axial length.
But some confusion exists between the terms “high myopia” and “pathologic myopia.” The former means “high myopic refractive error” and should be defined by refractive degree. However, the latter has staphylomas and characteristic fundus complications even without long axial length.
Thus, Curtin’s words have been proven to be true: “Posterior staphyloma may give us an unimpeachable basis for the genetic studies of myopia. ... The morphology of posterior staphyloma [c]ould be a much more reliable basis for genetic studies.”
Imaging modalities, like widefield OCT, used to visualize the wide extent of staphylomas are improving. Such improvements could exactly determine the staphylomas in a large population of patients. Quantitative and objective analyses of staphylomas could also become possible, which are important to establish treatment strategies.
“Pathologic myopia” is the only myopia responsible for decreasing BCVA due to its specific complications. Retina specialists have the privilege of seeing patients with pathologic myopia; thus it is expected that we should take a lead in the management of this vision-threatening disease. RP
REFERENCES
- Curtin BJ. The posterior staphyloma of pathologic myopia. Trans Am Ophthalmol Soc. 1977;75:67-86.
- Spaide RF. Staphyloma: Part 1. In: Spaide RF, Ohno-Matsui K, Yannuzzi LA, eds. Pathologic Myopia. New York, NY: Springer; 2014:167-176.
- Ohno-Matsui K, Moriyama M. Staphyloma II: analyses of morphological features of posterior staphyloma in pathologic myopia analyzed by a combination of wide-view fundus observation and 3D MRI analyses. In: Spaide RF, Ohno-Matsui K, Yannuzzi LA, eds. Pathologic Myopia. New York, NY: Springer; 2014: 177-185.
- Ohno-Matsui K. Proposed classification of posterior staphylomas based on analyses of eye shape by three-dimensional magnetic resonance imaging and wide-field fundus imaging. Ophthalmology. 2014;121:1798-1809.
- Ohno-Matsui K. What is the fundamental nature of pathologic myopia? Retina. 2016 Oct 10. [Epub ahead of print]
- Wang NK, Yu YM, Wang JP, et al. Clinical characteristics of posterior staphylomas in myopic eyes with axial length shorter than 26.5 mm. Am J Ophthalmol. 2016;162: 180-190.
- Moriyama M, Ohno-Matsui K, Hayashi K, et al. Topographic analyses of shape of eyes with pathologic myopia by high-resolution three-dimensional magnetic resonance imaging. Ophthalmology. 2011;118:1626-1637.
- Moriyama M, Ohno-Matsui K, Modegi T, et al. Quantitative analyses of high-resolution 3D MR images of highly myopic eyes to determine their shapes. Invest Ophthalmol Vis Sci. 2012;53:4510-4518.
- Ohno-Matsui K, Alkabes M, Salinas C, et al. Features of posterior staphylomas analzyed in wide-field fundus images in patients with unilateral and bilateral pathologic myopia. Retina. 2016 Aug 23. [Epub ahead of print]
- Curtin BJ. Ocular findings and complications. In: Curtin BJ, ed. The Myopias. New York, NY: Harper and Row; 1985:277-347.
- Liu S, Li S, Wang B, et al. Scleral cross-linking using riboflavin UVA irradiation for the prevention of myopia progression in a guinea pig model: blocked axial extension and altered scleral microstructure. PLoS One. 2016;11:e0165792.
- Shinohara K, et al. Establishment of novel therapy to reduce progression of myopia in rats with experimental myopia by fibroblast transplantation on sclera. J Tissue Eng Regen Med. In press.
- Jonas JB, Panda-Jonas S, Ohno-Matsui K. Bruch´s membrane and the mechanism of myopization: a new theory. Retina. In press.








